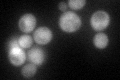
YNL274C
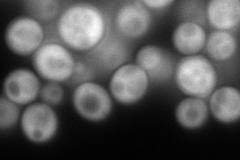
YNL274C
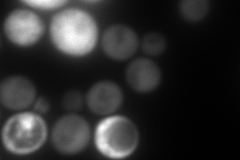
YNL274C
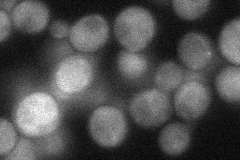
YNL274C
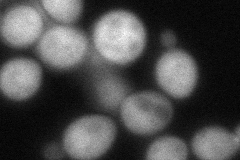
YNL274C
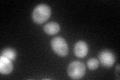
YNL274C

View description
Glyoxylate reductase; null mutation results in increased biomass after diauxic shift; the authentic, non-tagged protein is detected in highly purified mitochondria in high-throughput studies
Localization:
Intensity:
Fold change:
Significance:
-
C’ GFP library in SD
cytosol44.32 -
N' NOP1pr-GFP in SD
cytosol262.899 -
N' TEF2pr-mCherry in SD
cytosol303.823 -
N' NATIVEpr-GFP in SD
cytosol39.6847 -
N' TEF2pr-VC and Cyto-VN in SD
cytosol84.664 -
C’ GFP library in SD+DTT

cytosol39.590.89No -
C’ GFP library in SD+H2O2

cytosol60.081.35Yes -
C’ GFP library in Starvation Media
cytosol122.692.76Yes -
C’ GFP library on the background of Pup2-DaMP

cytosol -
C’ GFP library on the background of CCT mutant

cytosol34.47670.777692No
